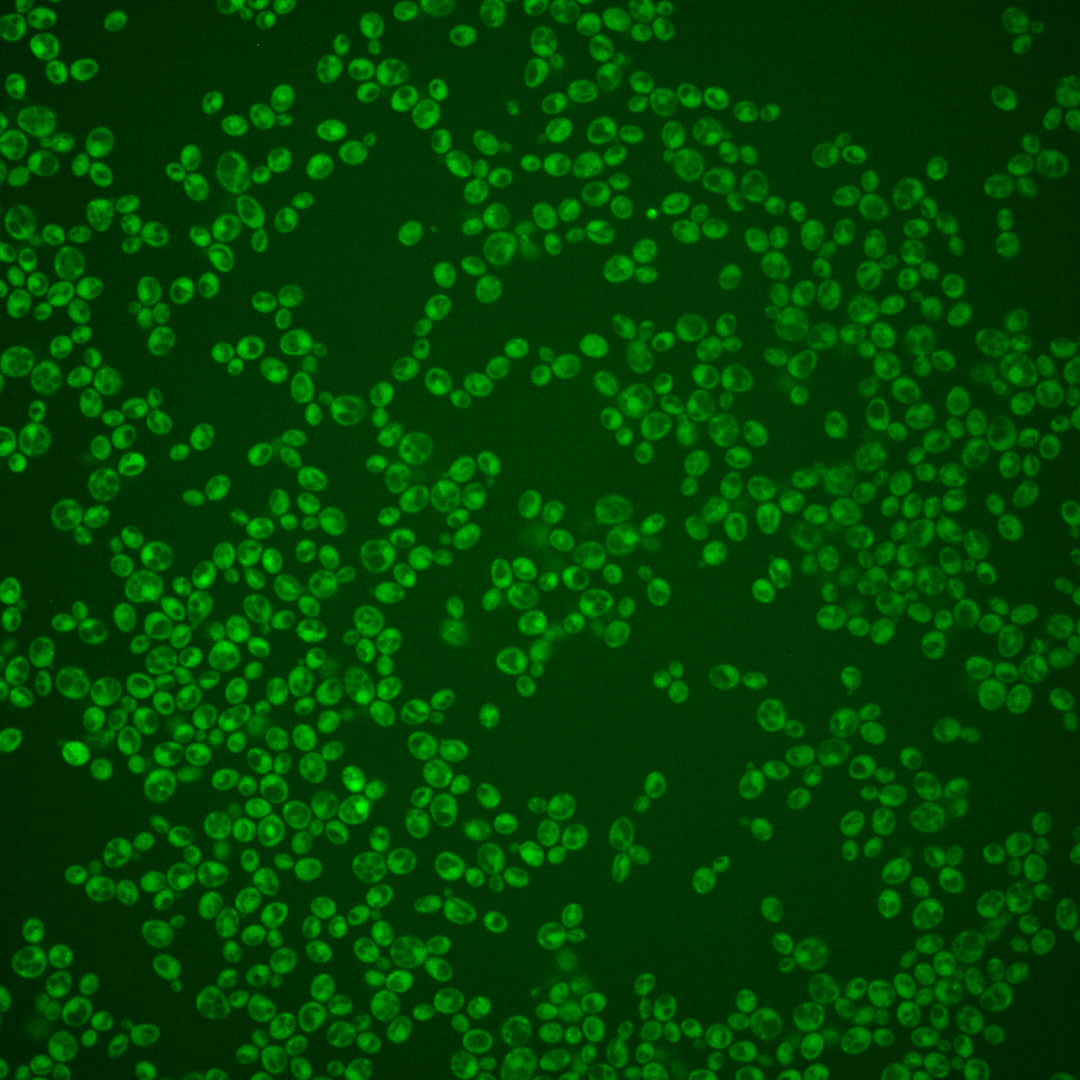
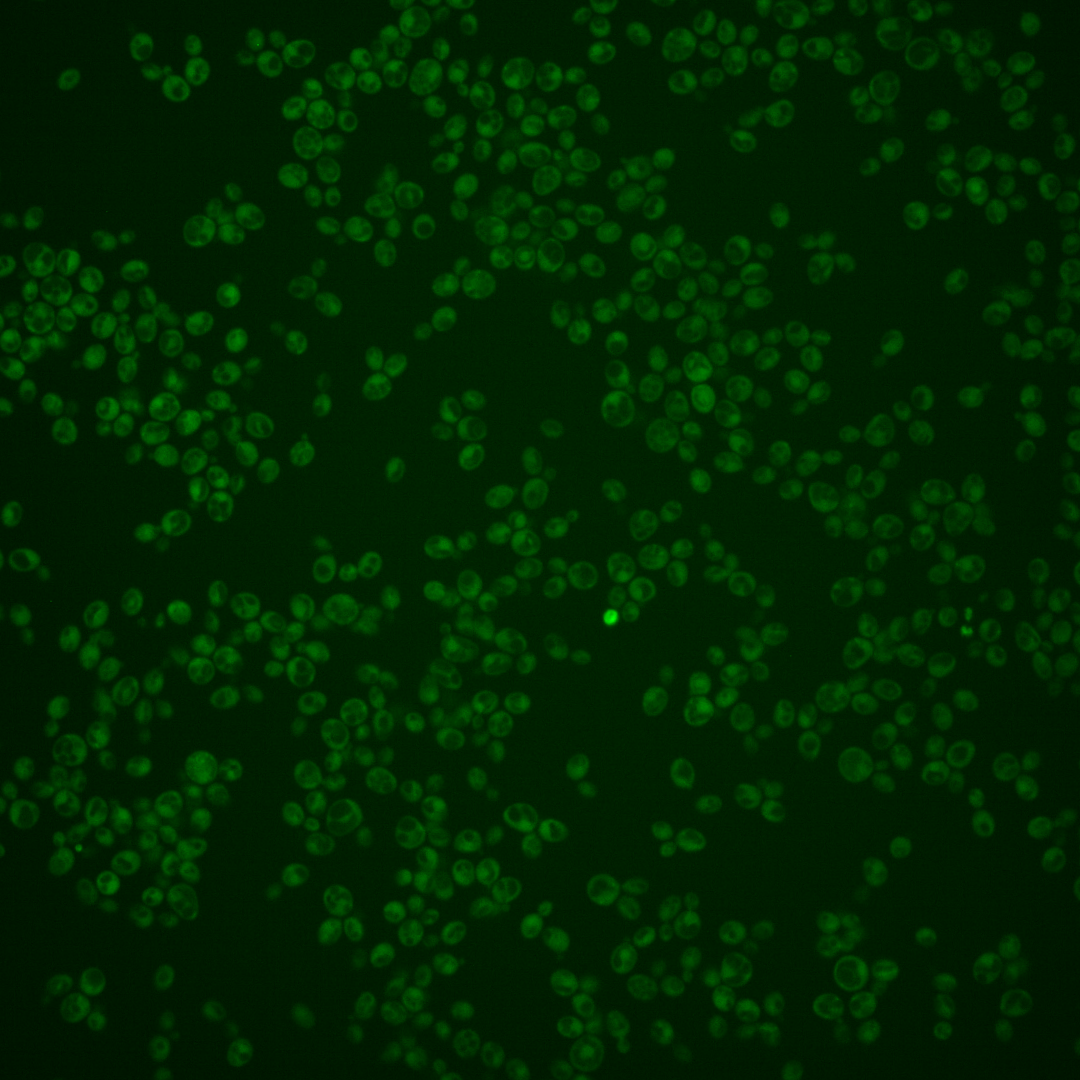

| Standard name | |
|---|---|
| Human Ortholog | |
| Description | Low-affinity inorganic phosphate (Pi) transporter; acts upstream of Pho81p in regulation of the PHO pathway; expression is independent of Pi concentration and Pho4p activity; contains 12 membrane-spanning segments; PHO87 has a paralog, PHO90, that arose from the whole genome duplication |
Micrographs




















































































Sub-cellular Localization
Yeast GFP Assignment
Protein Abundance
Localization Change
External localization resources
| ensLOC | DeepLoc | |||||||||||||||||||||||
|---|---|---|---|---|---|---|---|---|---|---|---|---|---|---|---|---|---|---|---|---|---|---|---|---|
| Localization | WT1 | WT2 | WT3 | RAP60 | RAP140 | RAP220 | RAP300 | RAP380 | RAP460 | RAP540 | RAP620 | RAP700 | HU80 | HU120 | HU160 | rpd3Δ_1 | rpd3Δ_2 | rpd3Δ_3 | WT1 | WT2 | WT3 | AF100 | AF140 | AF180 |
| Cortical Patches | 0 | 0 | 1 | 3 | 0 | 0 | 0 | 0 | – | 0 | 0 | 0 | 1 | 0 | 0 | – | – | – | 4 | 4 | 21 | 4 | 12 | 14 |
| Bud | 0 | 2 | 3 | 4 | 3 | 7 | 8 | 6 | – | 18 | 20 | 28 | 0 | 0 | 0 | – | – | – | 2 | 0 | 5 | 2 | 22 | 12 |
| Bud Neck | 0 | 1 | 4 | 0 | 1 | 0 | 1 | 2 | – | 3 | 1 | 1 | 1 | 2 | 2 | – | – | – | 1 | 3 | 5 | 1 | 8 | 8 |
| Bud Site | 0 | 0 | 0 | 0 | 0 | 0 | 0 | 1 | – | 1 | 4 | 2 | 0 | 0 | 0 | – | – | – | – | – | – | – | – | – |
| Cell Periphery | 3 | 3 | 1 | 2 | 0 | 4 | 7 | 3 | – | 4 | 1 | 3 | 4 | 11 | 3 | – | – | – | 1 | 3 | 8 | 4 | 12 | 9 |
| Cytoplasm | 194 | 259 | 423 | 272 | 464 | 560 | 748 | 715 | – | 587 | 314 | 485 | 262 | 264 | 380 | – | – | – | 127 | 223 | 217 | 112 | 357 | 328 |
| Endoplasmic Reticulum | 0 | 6 | 2 | 5 | 1 | 3 | 3 | 0 | – | 0 | 1 | 2 | 8 | 5 | 2 | – | – | – | 23 | 12 | 48 | 12 | 14 | 28 |
| Endosome | 0 | 0 | 1 | 1 | 13 | 7 | 12 | 9 | – | 0 | 1 | 1 | 0 | 0 | 0 | – | – | – | 1 | 2 | 7 | 0 | 8 | 5 |
| Golgi | 0 | 0 | 0 | 0 | 0 | 0 | 0 | 0 | – | 0 | 0 | 0 | 1 | 0 | 0 | – | – | – | 0 | 1 | 1 | 0 | 0 | 0 |
| Mitochondria | 1 | 8 | 6 | 12 | 29 | 167 | 276 | 250 | – | 347 | 270 | 430 | 0 | 0 | 0 | – | – | – | 23 | 21 | 96 | 32 | 64 | 56 |
| Nucleus | 0 | 0 | 3 | 2 | 1 | 0 | 5 | 6 | – | 5 | 1 | 3 | 0 | 0 | 1 | – | – | – | 0 | 0 | 0 | 0 | 1 | 0 |
| Nuclear Periphery | 0 | 0 | 0 | 2 | 0 | 0 | 0 | 2 | – | 2 | 1 | 2 | 0 | 0 | 0 | – | – | – | 0 | 0 | 2 | 0 | 1 | 0 |
| Nucleolus | 0 | 0 | 0 | 0 | 0 | 0 | 0 | 0 | – | 2 | 0 | 1 | 0 | 0 | 0 | – | – | – | 0 | 0 | 0 | 0 | 0 | 0 |
| Peroxisomes | 0 | 0 | 0 | 0 | 1 | 0 | 0 | 3 | – | 0 | 0 | 0 | 0 | 0 | 0 | – | – | – | 0 | 0 | 1 | 0 | 0 | 0 |
| SpindlePole | 1 | 1 | 1 | 2 | 5 | 3 | 8 | 7 | – | 12 | 12 | 14 | 0 | 0 | 0 | – | – | – | 1 | 2 | 4 | 0 | 7 | 7 |
| Vac/Vac Membrane | 2 | 0 | 0 | 1 | 17 | 19 | 33 | 18 | – | 17 | 6 | 12 | 0 | 0 | 0 | – | – | – | 1 | 3 | 6 | 4 | 20 | 18 |
| Unique Cell Count | 196 | 274 | 436 | 294 | 506 | 677 | 949 | 904 | 811 | 480 | 780 | 271 | 270 | 382 | 194 | 286 | 442 | 182 | 545 | 505 | ||||
| Labelled Cell Count | 201 | 280 | 445 | 306 | 535 | 770 | 1101 | 1022 | 998 | 632 | 984 | 277 | 282 | 388 | 194 | 286 | 442 | 182 | 545 | 505 | ||||
Yeast GFP Assignment
Protein Abundance
| Screen | WT1 | WT2 | WT3 | RAP60 | RAP140 | RAP220 | RAP300 | RAP380 | RAP460 | RAP540 | RAP620 | RAP700 | HU80 | HU120 | HU160 | rpd3Δ_1 | rpd3Δ_2 | rpd3Δ_3 | AF100 | AF140 | AF180 |
|---|---|---|---|---|---|---|---|---|---|---|---|---|---|---|---|---|---|---|---|---|---|
| Mean Cell GFP Intensity (1e-4) | 4.6 | 3.8 | 3.9 | 4.3 | 4.3 | 3.5 | 3.3 | 3.5 | – | 3.0 | 3.1 | 3.0 | 5.2 | 5.1 | 5.3 | – | 4.1 | 4.9 | 5.5 | 5.5 | 5.7 |
| Std Deviation (1e-4) | 2.1 | 0.6 | 1.2 | 1.9 | 1.8 | 1.3 | 1.3 | 1.1 | – | 1.0 | 1.3 | 0.9 | 0.8 | 0.8 | 1.0 | – | 1.2 | 1.5 | 1.5 | 1.7 | 1.8 |
| Intensity Change (Log2) | – | – | – | 0.14 | 0.14 | -0.17 | -0.24 | -0.13 | – | -0.36 | -0.32 | -0.36 | 0.44 | 0.4 | 0.46 | – | 0.07 | 0.33 | 0.5 | 0.51 | 0.56 |
Localization Change
| Localization | RAP60 | RAP140 | RAP220 | RAP300 | RAP380 | RAP460 | RAP540 | RAP620 | RAP700 | HU80 | HU120 | HU160 | rpd3Δ_1 | rpd3Δ_2 | rpd3Δ_3 |
|---|---|---|---|---|---|---|---|---|---|---|---|---|---|---|---|
| Actin | – | – | – | – | – | – | – | – | – | – | – | – | – | – | – |
| Bud | – | – | – | – | – | – | – | – | – | – | – | – | – | – | – |
| Bud Neck | – | – | – | – | – | – | – | – | – | – | – | – | – | – | – |
| Bud Site | – | – | – | – | – | – | – | – | – | – | – | – | – | – | – |
| Cell Periphery | – | – | – | – | – | – | – | – | – | – | – | – | – | – | – |
| Cyto | – | – | – | – | – | – | – | – | – | – | – | – | – | – | – |
| Endoplasmic Reticulum | – | – | – | – | – | – | – | – | – | – | – | – | – | – | – |
| Endosome | – | – | – | – | – | – | – | – | – | – | – | – | – | – | – |
| Golgi | – | – | – | – | – | – | – | – | – | – | – | – | – | – | – |
| Mitochondria | – | – | – | – | – | – | – | – | – | – | – | – | – | – | – |
| Nuclear Periphery | – | – | – | – | – | – | – | – | – | – | – | – | – | – | – |
| Nuc | – | – | – | – | – | – | – | – | – | – | – | – | – | – | – |
| Nucleolus | – | – | – | – | – | – | – | – | – | – | – | – | – | – | – |
| Peroxisomes | – | – | – | – | – | – | – | – | – | – | – | – | – | – | – |
| SpindlePole | – | – | – | – | – | – | – | – | – | – | – | – | – | – | – |
| Vac | – | – | – | – | – | – | – | – | – | – | – | – | – | – | – |
| Cortical Patches | – | – | – | – | – | – | – | – | – | – | – | – | – | – | – |
| Cytoplasm | – | – | – | – | – | – | – | – | – | – | – | – | – | – | – |
| Nucleus | – | – | – | – | – | – | – | – | – | – | – | – | – | – | – |
| Vacuole | – | – | – | – | – | – | – | – | – | – | – | – | – | – | – |
External localization resources
Images






























Protein Concentration and Protein Localization Data
| R1 | R2 | R3 | ||||||||||||||||
|---|---|---|---|---|---|---|---|---|---|---|---|---|---|---|---|---|---|---|
| G1 Pre-START | G1 Post-START | S/G2 | Metaphase | Anaphase | Telophase | G1 Pre-START | G1 Post-START | S/G2 | Metaphase | Anaphase | Telophase | G1 Pre-START | G1 Post-START | S/G2 | Metaphase | Anaphase | Telophase | |
| Concentration | 1.5026 | 2.0799 | 2.2047 | 2.439 | 1.2167 | 2.0275 | 1.6501 | 1.759 | 1.3982 | 1.6667 | 1.5495 | 1.2239 | 0.7869 | 1.161 | 1.0763 | 0.7142 | 0.1747 | 0.8851 |
| Actin | 0.0093 | 0.0036 | 0.0121 | 0.0125 | 0.0044 | 0.0023 | 0.0969 | 0.0074 | 0.0487 | 0.0035 | 0.0173 | 0.0035 | 0.1002 | 0.0058 | 0.0232 | 0.0495 | 0.0011 | 0.0028 |
| Bud | 0.0001 | 0.0003 | 0.0003 | 0.0003 | 0.0002 | 0.0001 | 0.0008 | 0.0002 | 0.002 | 0.0137 | 0.0001 | 0.0042 | 0.0007 | 0.0002 | 0.0008 | 0.0012 | 0 | 0.0001 |
| Bud Neck | 0.0013 | 0.0008 | 0.0008 | 0.0018 | 0.0015 | 0.0038 | 0.0028 | 0.0005 | 0.0022 | 0.0004 | 0.0004 | 0.0027 | 0.0012 | 0.001 | 0.0017 | 0.0012 | 0.0005 | 0.001 |
| Bud Periphery | 0.0003 | 0.0006 | 0.0005 | 0.0003 | 0.0003 | 0.0001 | 0.001 | 0.0003 | 0.0037 | 0.0356 | 0.0001 | 0.0015 | 0.001 | 0.0002 | 0.0007 | 0.002 | 0 | 0.0001 |
| Bud Site | 0.0005 | 0.0117 | 0.003 | 0.0008 | 0.0008 | 0.0002 | 0.0025 | 0.0035 | 0.0078 | 0.0017 | 0.0004 | 0.0002 | 0.0048 | 0.0062 | 0.0223 | 0.0037 | 0 | 0.0002 |
| Cell Periphery | 0.0009 | 0.003 | 0.0016 | 0.0006 | 0.0011 | 0.0005 | 0.0012 | 0.004 | 0.0018 | 0.0012 | 0.0004 | 0.0007 | 0.001 | 0.0047 | 0.0029 | 0.0013 | 0.0005 | 0.0002 |
| Cytoplasm | 0.3868 | 0.4234 | 0.4604 | 0.4089 | 0.5247 | 0.4472 | 0.2012 | 0.3638 | 0.3503 | 0.1648 | 0.4757 | 0.4351 | 0.229 | 0.4782 | 0.3252 | 0.4591 | 0.3146 | 0.3604 |
| Cytoplasmic Foci | 0.0235 | 0.0209 | 0.0237 | 0.0069 | 0.0219 | 0.016 | 0.0233 | 0.0136 | 0.0381 | 0.0203 | 0.0235 | 0.0098 | 0.0172 | 0.0192 | 0.0381 | 0.0167 | 0.0052 | 0.0195 |
| Eisosomes | 0.0007 | 0.0004 | 0.0003 | 0.0002 | 0.0001 | 0.0001 | 0.0006 | 0.0009 | 0.0028 | 0.0004 | 0.0002 | 0.0002 | 0.0007 | 0.0001 | 0.0003 | 0.0002 | 0.0001 | 0 |
| Endoplasmic Reticulum | 0.1649 | 0.176 | 0.1945 | 0.2754 | 0.1782 | 0.2677 | 0.0941 | 0.2528 | 0.2099 | 0.3232 | 0.3448 | 0.238 | 0.3568 | 0.1499 | 0.343 | 0.2166 | 0.3388 | 0.3621 |
| Endosome | 0.0236 | 0.0221 | 0.0278 | 0.018 | 0.0263 | 0.0146 | 0.0489 | 0.0082 | 0.0214 | 0.0791 | 0.0058 | 0.0129 | 0.0302 | 0.0472 | 0.0182 | 0.0451 | 0.0124 | 0.0234 |
| Golgi | 0.0028 | 0.002 | 0.0054 | 0.0012 | 0.0038 | 0.0011 | 0.0181 | 0.0044 | 0.0176 | 0.0318 | 0.0021 | 0.002 | 0.0155 | 0.0032 | 0.013 | 0.0178 | 0.0013 | 0.0064 |
| Lipid Particles | 0.0107 | 0.0077 | 0.0069 | 0.003 | 0.0074 | 0.0033 | 0.0296 | 0.014 | 0.0114 | 0.008 | 0.0059 | 0.0021 | 0.0195 | 0.021 | 0.0074 | 0.0055 | 0.0108 | 0.0141 |
| Mitochondria | 0.0016 | 0.0008 | 0.001 | 0.0016 | 0.0007 | 0.0008 | 0.0065 | 0.0004 | 0.0075 | 0.0072 | 0.0003 | 0.0162 | 0.0057 | 0.0003 | 0.0324 | 0.0047 | 0.0001 | 0.002 |
| None | 0.3489 | 0.3039 | 0.2372 | 0.2354 | 0.1866 | 0.2274 | 0.3777 | 0.3191 | 0.2501 | 0.2912 | 0.1161 | 0.26 | 0.1871 | 0.2491 | 0.1501 | 0.1451 | 0.3094 | 0.1913 |
| Nuclear Periphery | 0.0103 | 0.0072 | 0.0069 | 0.0156 | 0.0167 | 0.0068 | 0.0596 | 0.0024 | 0.0026 | 0.0055 | 0.0023 | 0.0042 | 0.01 | 0.0068 | 0.0049 | 0.0153 | 0.0031 | 0.004 |
| Nucleolus | 0.0003 | 0.0005 | 0.0005 | 0.0003 | 0.0004 | 0.0001 | 0.001 | 0.0002 | 0.0001 | 0.0005 | 0.0001 | 0.0001 | 0.0006 | 0.0001 | 0.0002 | 0.0002 | 0 | 0.0003 |
| Nucleus | 0.0028 | 0.0043 | 0.0034 | 0.0095 | 0.0113 | 0.0032 | 0.0153 | 0.0008 | 0.0009 | 0.0015 | 0.0007 | 0.0027 | 0.0019 | 0.0014 | 0.001 | 0.0029 | 0.0005 | 0.0011 |
| Peroxisomes | 0.0012 | 0.0008 | 0.0015 | 0.0005 | 0.0008 | 0.0003 | 0.0051 | 0.0005 | 0.0171 | 0.0028 | 0.0022 | 0.0002 | 0.0048 | 0.0002 | 0.0022 | 0.0011 | 0 | 0.0016 |
| Punctate Nuclear | 0.0037 | 0.0021 | 0.0067 | 0.0022 | 0.0065 | 0.0011 | 0.0054 | 0.0008 | 0.0016 | 0.0014 | 0.0007 | 0.001 | 0.0084 | 0.0012 | 0.0099 | 0.0022 | 0.0003 | 0.0074 |
| Vacuole | 0.0048 | 0.0075 | 0.0049 | 0.0043 | 0.0058 | 0.0031 | 0.0044 | 0.0021 | 0.0022 | 0.0048 | 0.0009 | 0.0024 | 0.003 | 0.0036 | 0.0022 | 0.0068 | 0.001 | 0.0017 |
| Vacuole Periphery | 0.0008 | 0.0006 | 0.0005 | 0.0007 | 0.0005 | 0.0004 | 0.004 | 0.0002 | 0.0003 | 0.0014 | 0.0001 | 0.0004 | 0.0009 | 0.0004 | 0.0004 | 0.0019 | 0.0001 | 0.0003 |
Sequencing Data
| R1 | R2 | |||||||||
|---|---|---|---|---|---|---|---|---|---|---|
| G1 Post-START | S/G2 | Metaphase | Anaphase | Telophase | G1 Post-START | S/G2 | Metaphase | Anaphase | Telophase | |
| Gene Expression | 18.9075 | 19.9268 | 20.8596 | 18.5603 | 14.1926 | 18.3003 | 24.1955 | 23.9188 | 21.4851 | 18.7077 |
| Translational Efficiency | 0.481 | 0.6495 | 0.3296 | 0.3165 | 0.6089 | 0.478 | 0.444 | 0.3607 | 0.3189 | 0.4688 |
Hit Data
| Dataset | Hit |
|---|---|
| Protein Concentration | ✘ |
| Protein Localization | ✘ |
| Gene Expression | ✔ |
| Translational Efficiency | ✘ |
Endocytosis
| Temp | Actin Patch (Sac6-tdTomato) | Cortical Patch (Sla1-GFP) | Late Endosome (Snf7-GFP) | Vacuole (Vph1-GFP) |
|---|---|---|---|---|
| 37℃ | ||||
| RT |
Cell Cycle Omics
CYCLoPs (Pho87-GFP)
| Gene / Allele | Actin Patch (Sac6-tdTomato) | Cortical Patch (Sla1-GFP) | Late Endosome (Snf7-GFP) | Vacuole (Sac6-tdTomato) |
|---|
| Gene | Images |
|---|
| Gene | Images |
|---|
Images are not yet available
Images are not yet available